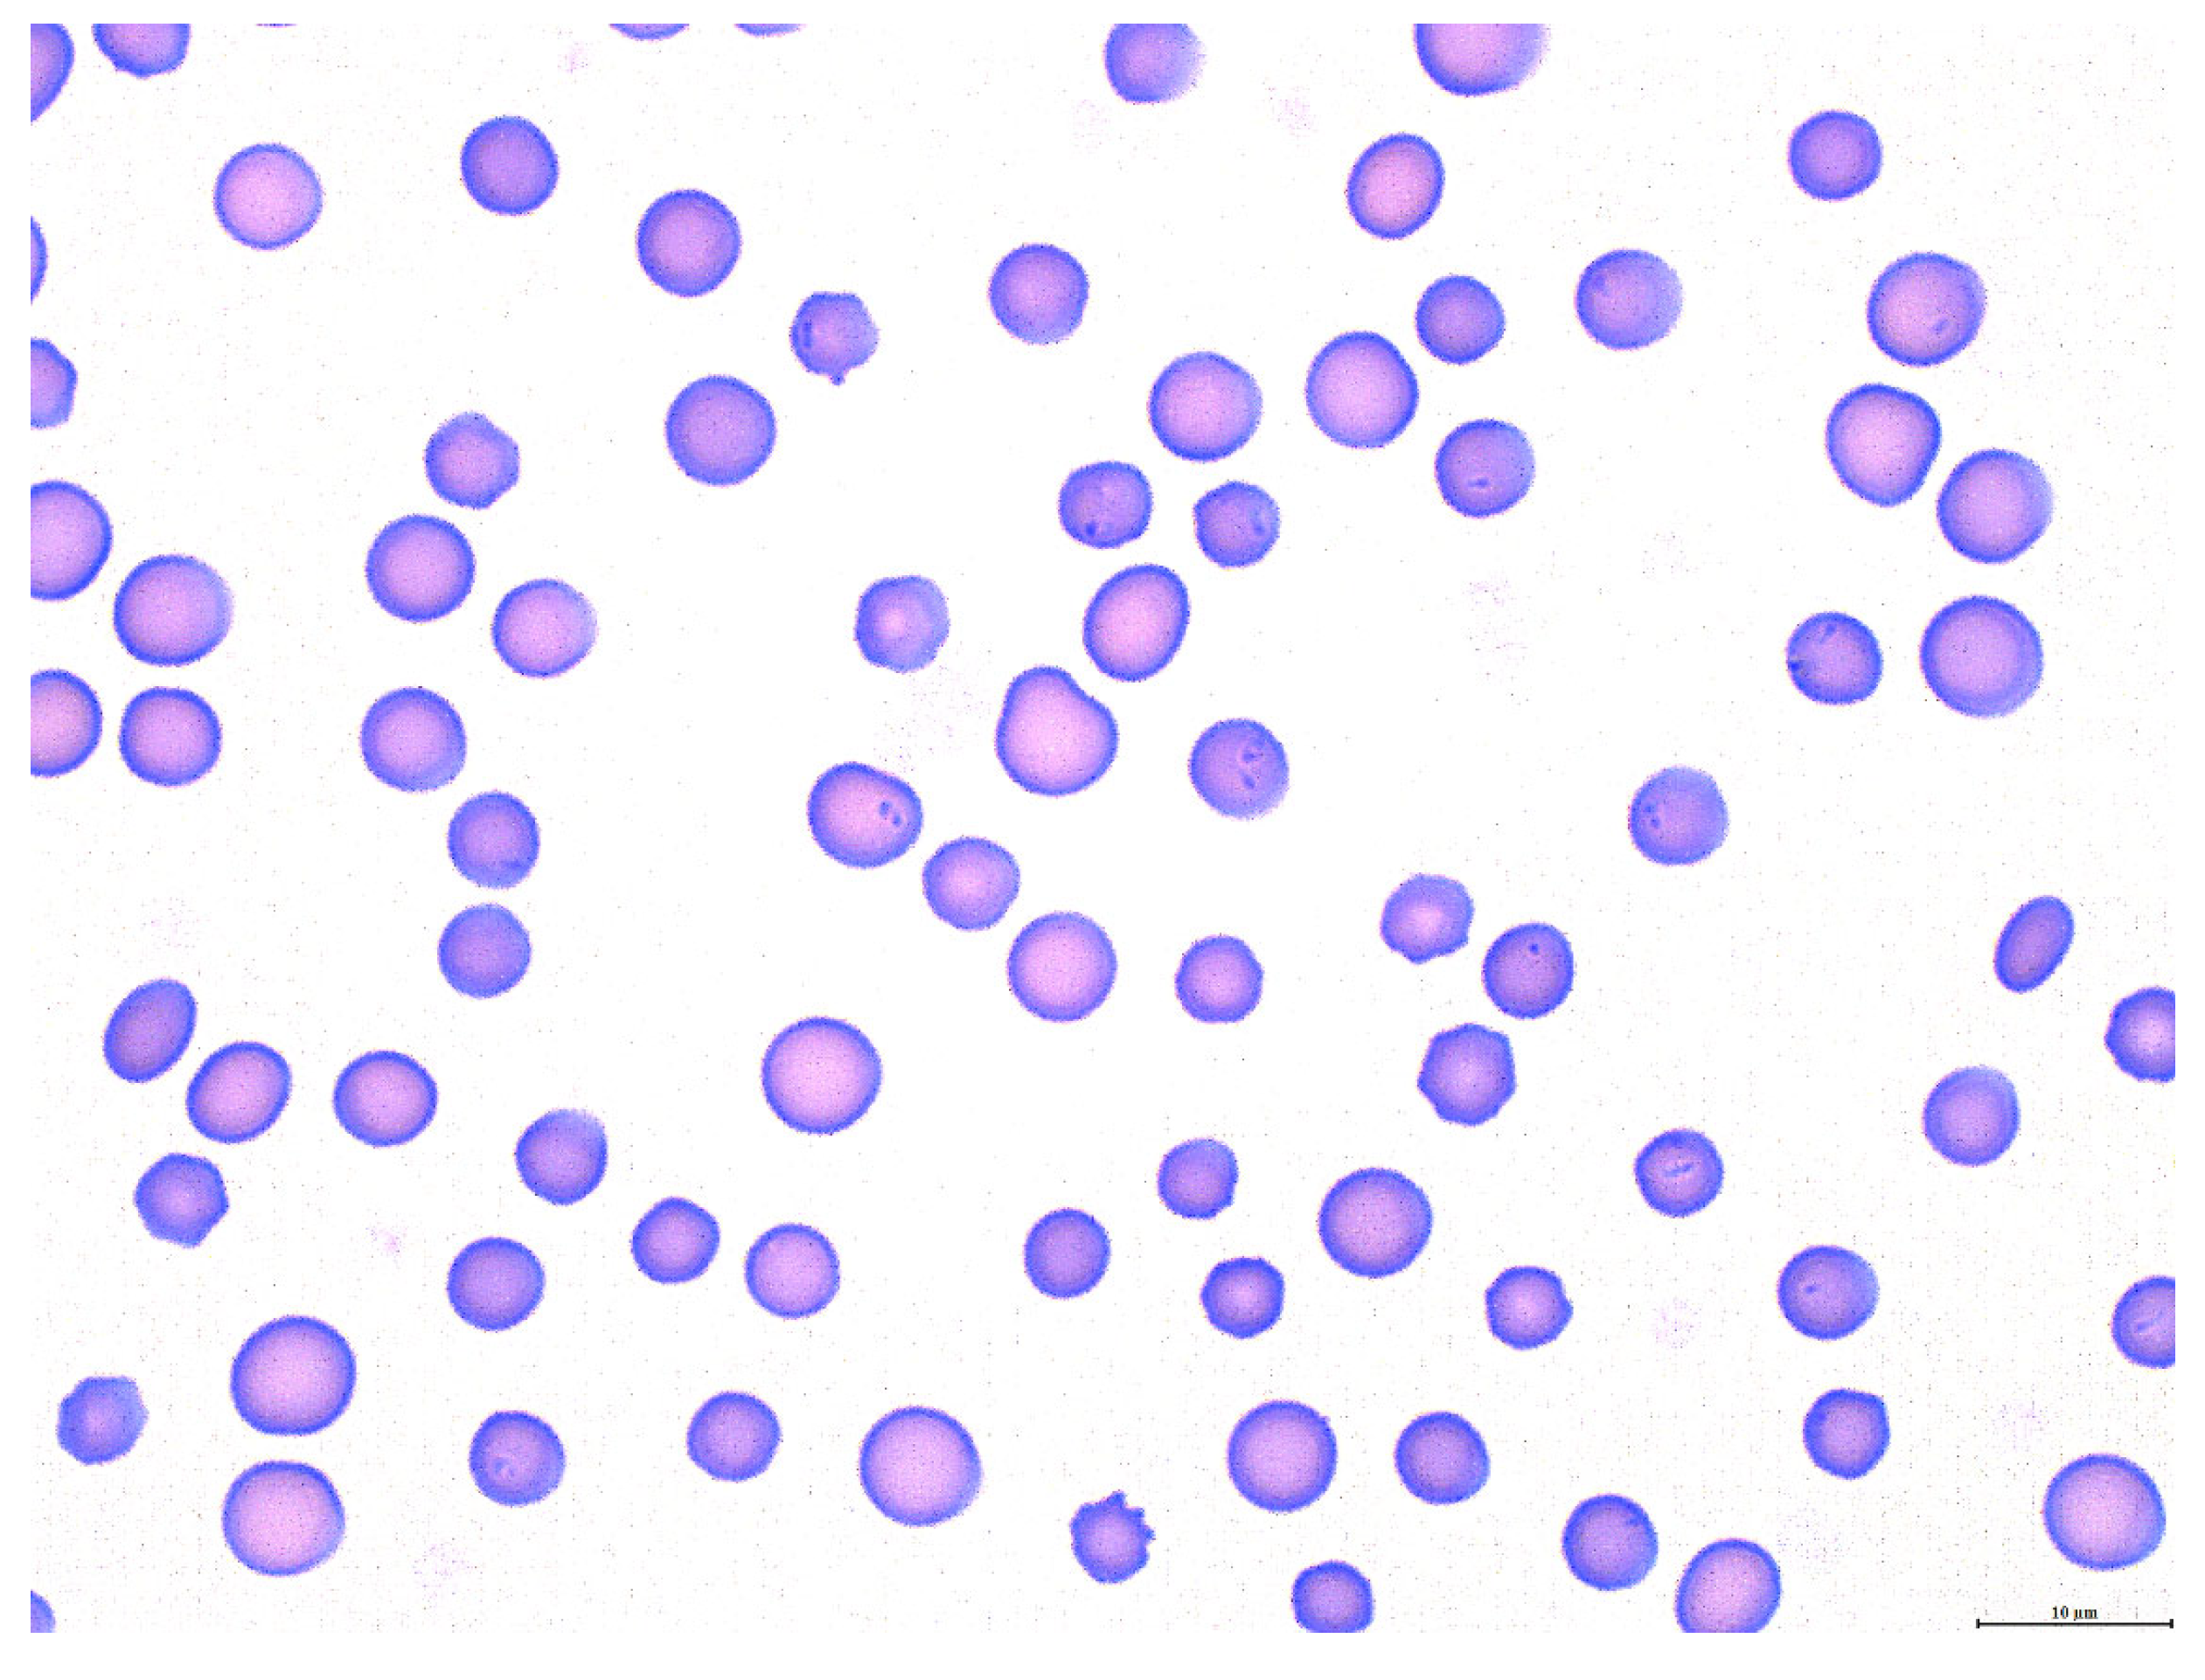

A U.S. Isolate of Theileria orientalis Ikeda Is Not Transstadially Transmitted to Cattle by Rhipicephalus microplus
Abstract
1. Introduction
2. Materials and Methods
2.1. Cattle
2.2. Infection of Calf 1 with Theileria orientalis Stabilate
2.3. Theileria orientalis DNA Isolation
2.4. Theileria orientalis PCR
2.5. Acquisition Feeding of Rhipicephalus microplus Ticks on Calf 1
2.6. Transmission Feeding of Rhipicephalus microplus Ticks on Calves 2 and 3
2.7. Assessment of Progeny Larval Ticks for Theileria orientalis Infection
3. Results
3.1. Theileria orientalis Infection of Calf 1
3.2. Rhipicephalus microplus Acquisition Feed on Calf 1
3.3. Failure of Adult R. microplus Ticks to Transmit T. orientalis to Calves 2 and 3
3.4. T. orientalis Is Not Detected in Larval Progeny of R. microplus Fed on an Infected Calf
4. Discussion
Author Contributions
Funding
Institutional Review Board Statement
Informed Consent Statement
Data Availability Statement
Acknowledgments
Conflicts of Interest
References
- Sivakumar, T.; Hayashida, K.; Sugimoto, C.; Yokoyama, N. Evolution and genetic diversity of Theileria. Infect. Genet. Evol. 2014, 27, 250–263. [Google Scholar] [CrossRef] [PubMed]
- Watts, J.G.; Playford, M.C.; Hickey, K.L. Theileria orientalis: A review. N. Z. Vet. J. 2016, 64, 3–9. [Google Scholar] [CrossRef] [PubMed]
- Lawrence, K.; Forsyth, S.; Vaatstra, B.; McFadden, A.; Pulford, D.; Govindaraju, K.; Pomroy, W. Clinical haematology and biochemistry profiles of cattle naturally infected with Theileria orientalis Ikeda type in New Zealand. N. Z. Vet. J. 2017, 66, 21–29. [Google Scholar] [CrossRef] [PubMed]
- Lawrence, K.; Gedye, K.; Pomroy, W. A longitudinal study of the effect of Theileria orientalis Ikeda type infection on three New Zealand dairy farms naturally infected at pasture. Vet. Parasitol. 2019, 276, 108977. [Google Scholar] [CrossRef] [PubMed]
- Lawrence, K.; Gibson, M.; Hickson, R.; Gedye, K.; Hoogenboom, A.; Fermin, L.; Draganova, I.; Pomroy, W. Experimental infection of Friesian bulls with Theileria orientalis (Ikeda) and effects on the haematocrit, live weight, rectal temperature and activity. Vet. Parasitol. Reg. Stud. Rep. 2018, 14, 85–93. [Google Scholar] [CrossRef]
- Lawrence, K.; Lawrence, B.; Hickson, R.; Hewitt, C.; Gedye, K.; Fermin, L.; Pomroy, W. Associations between Theileria orientalis Ikeda type infection and the growth rates and haematocrit of suckled beef calves in the North Island of New Zealand. N. Z. Vet. J. 2018, 67, 66–73. [Google Scholar] [CrossRef]
- Perera, P.K.; Gasser, R.B.; Firestone, S.M.; Anderson, G.A.; Malmo, J.; Davis, G.; Beggs, D.S.; Jabbar, A. Oriental theileriosis in dairy cows causes a significant milk production loss. Parasites Vectors 2014, 7, 73. [Google Scholar] [CrossRef]
- Oakes, V.J.; Yabsley, M.J.; Schwartz, D.; LeRoith, T.; Bissett, C.; Broaddus, C.; Schlater, J.L.; Todd, S.M.; Boes, K.M.; Brookhart, M.; et al. Theileria orientalis Ikeda Genotype in Cattle, Virginia, USA. Emerg. Infect. Dis. 2019, 25, 1653–1659. [Google Scholar] [CrossRef]
- Eamens, G.J.; Bailey, G.; Jenkins, C.; Gonsalves, J.R. Significance of Theileria orientalis types in individual affected beef herds in New South Wales based on clinical, smear and PCR findings. Vet. Parasitol. 2013, 196, 96–105. [Google Scholar] [CrossRef]
- Eamens, G.J.; Gonsalves, J.R.; Jenkins, C.; Collins, D.; Bailey, G. Theileria orientalis MPSP types in Australian cattle herds associated with outbreaks of clinical disease and their association with clinical pathology findings. Vet. Parasitol. 2013, 191, 209–217. [Google Scholar] [CrossRef]
- Telionis, A.; Lahmers, K.; Todd, M.; Carbonello, A.; Broaddus, C.C.; Bissett, C.J.; Hungerford, L.L. Distribution of Theileria orientalis in Virginia Market Cattle, 2018–2020. Pathogens 2022, 11, 1353. [Google Scholar] [CrossRef]
- Uilenberg, G.; Perié, N.M.; Spanjer, A.A.; Franssen, F.F. Theileria orientalis, a cosmopolitan blood parasite of cattle: Demonstration of the schizont stage. Res. Vet. Sci. 1985, 38, 352–360. [Google Scholar] [CrossRef]
- Stockham, S.L.; Kjemtrup, A.M.; Conrad, P.A.; Schmidt, D.A.; Scott, M.A.; Robinson, T.W.; Tyler, J.W.; Johnson, G.C.; Carson, C.A.; Cuddihee, P. Theileriosis in a Missouri beef herd caused by Theileria buffeli: Case report, herd investigation, ultra-structure, phylogenetic analysis, and experimental transmission. Vet. Pathol. 2000, 37, 11–21. [Google Scholar] [CrossRef]
- Oakes, V.J.; Todd, S.M.; Carbonello, A.A.; Michalak, P.; Lahmers, K.K. Coinfection of cattle in Virginia with Theileria orientalis Ikeda genotype and Anaplasma marginale. J. Vet. Diagn. Investig. 2021, 34, 36–41. [Google Scholar] [CrossRef]
- Thompson, A.T.; White, S.; Shaw, D.; Egizi, A.; Lahmers, K.; Ruder, M.G.; Yabsley, M.J. Theileria orientalis Ikeda in host-seeking Haemaphysalis longicornis in Virginia, U.S.A. Ticks Tick-Borne Dis. 2020, 11, 101450. [Google Scholar] [CrossRef]
- Lokting, B. A New Tick-Borne Disease Is Killing Cattle in the US. MIT Technology Review 2022. Available online: https://www.technologyreview.com/2022/11/17/1063352/new-tick-borne-disease-killing-cattle-in-us/ (accessed on 18 February 2023).
- Dinkel, K.D.; Herndon, D.R.; Noh, S.M.; Lahmers, K.K.; Todd, S.M.; Ueti, M.W.; Scoles, G.A.; Mason, K.L.; Fry, L.M. A U.S. isolate of Theileria orientalis, Ikeda genotype, is transmitted to cattle by the invasive Asian longhorned tick, Haemaphysalis longicornis. Parasites Vectors 2021, 14, 157. [Google Scholar] [CrossRef]
- Marendy, D.; Baker, K.; Emery, D.; Rolls, P.; Stutchbury, R. Haemaphysalis longicornis: The life-cycle on dogs and cattle, with confirmation of its vector status for Theileria orientalis in Australia. Vet. Parasitol. 2019, 277, 100022. [Google Scholar] [CrossRef]
- Heath, A. Biology, ecology and distribution of the tick, Haemaphysalis longicornis Neumann (Acari: Ixodidae) in New Zealand. N. Z. Vet. J. 2016, 64, 10–20. [Google Scholar] [CrossRef]
- Rainey, T.; Occi, J.L.; Robbins, R.G.; Egizi, A. Discovery of Haemaphysalis longicornis (Ixodida: Ixodidae) Parasitizing a Sheep in New Jersey, United States. J. Med. Èntomol. 2018, 55, 757–759. [Google Scholar] [CrossRef]
- Tufts, D.M.; VanAcker, M.C.; Fernandez, M.P.; DeNicola, A.; Egizi, A.; Diuk-Wasser, M.A. Distribution, Host-Seeking Phenology, and Host and Habitat Associations of Haemaphysalis longicornis Ticks, Staten Island, New York, USA. Emerg. Infect. Dis. 2019, 25, 792–796. [Google Scholar] [CrossRef]
- Beard, C.B.; Occi, J.; Bonilla, D.L.; Egizi, A.M.; Fonseca, D.M.; Mertins, J.W.; Backenson, B.P.; Bajwa, W.I.; Barbarin, A.M.; Bertone, M.A.; et al. Multistate Infestation with the Exotic Disease-Vector Tick Haemaphysalis longicornis—United States, August 2017-September 2018. MMWR Morb. Mortal. Wkly. Rep. 2018, 67, 1310–1313. [Google Scholar] [CrossRef] [PubMed]
- Bonilla, D.L. National Haemaphysalis longicornis (Asian Longhorned Tick) Situation Report, USDA-APHIS, Service, Editor. 2-27-2023, USDA-APHIS. Available online: https://www.aphis.usda.gov/animal_health/animal_diseases/tick/downloads/longhorned-tick-sitrep.pdf (accessed on 28 February 2023).
- Hammer, J.F.; Jenkins, C.; Bogema, D.; Emery, D. Mechanical transfer of Theileria orientalis: Possible roles of biting arthropods, colostrum and husbandry practices in disease transmission. Parasites Vectors 2016, 9, 34. [Google Scholar] [CrossRef] [PubMed]
- Fujusaki, K.; Kamio, T.; Kawazu, S.; Shimizu, S.; Shimura, K. Theileria sergenti: Experimental transmission by the long-nosed cattle louse, Linognathus vituli. Ann. Trop. Med. Parasitol. 1993, 87, 217–218. [Google Scholar] [CrossRef] [PubMed]
- Alkishe, A.; Raghavan, R.K.; Peterson, A.T. Likely Geographic Distributional Shifts among Medically Important Tick Species and Tick-Associated Diseases under Climate Change in North America: A Review. Insects 2021, 12, 225. [Google Scholar] [CrossRef] [PubMed]
- Howell, J.M.; Ueti, M.W.; Palmer, G.H.; Scoles, G.A.; Knowles, D.P. Persistently Infected Calves as Reservoirs for Acquisition and Transovarial Transmission of Babesia bovis by Rhipicephalus (Boophilus) microplus. J. Clin. Microbiol. 2007, 45, 3155–3159. [Google Scholar] [CrossRef]
- Mahoney, D.F.; Wright, I.G.; Goodger, B.V.; Mirre, G.B.; Sutherst, R.W.; Utech, K.B.W. The transmission of babesia bovis in herds of european and zebu x european cattle infested with the tick, boophilus microplus. Aust. Vet. J. 1981, 57, 461–469. [Google Scholar] [CrossRef]
- Potgieter, F.T.; Van Vuuren, A.S. The transmission of Babesia bovis using frozen infective material obtained from Boophilus microplus larvae. Onderstepoort J. Vet. Res. 1974, 41, 79–80. [Google Scholar]
- Scoles, G.A.; Ueti, M.W. Vector Ecology of Equine Piroplasmosis. Annu. Rev. Èntomol. 2015, 60, 561–580. [Google Scholar] [CrossRef]
- Uilenberg, G. Babesia—A historical overview. Vet. Parasitol. 2006, 138, 3–10. [Google Scholar] [CrossRef]
- Annual Cattle Review, Texas and U.S. Inventory, USDA-NASS, Editor. 2021: Texas Field Office. Available online: https://www.nass.usda.gov/Statistics_by_State/Texas/Publications/Current_News_Release/2021_Rls/tx-cattle-review-2021.pdf (accessed on 5 February 2023).
- Kakati, P.; Sarmah, P.C.; Ray, D.; Bhattacharjee, K.; Sharma, R.K.; Barkalita, L.M.; Sarma, D.K.; Baishya, B.C.; Borah, P.; Stanley, B. Emergence of oriental theileriosis in cattle and its transmission through Rhipicephalus (Boophilus) microplus in Assam, India. Vet. World 2015, 8, 1099–1104. [Google Scholar] [CrossRef]
- Li, L.-H.; Wang, J.-Z.; Zhu, D.; Li, X.-S.; Lu, Y.; Yin, S.-Q.; Li, S.-G.; Zhang, Y.; Zhou, X.-N. Detection of novel piroplasmid species and Babesia microti and Theileria orientalis genotypes in hard ticks from Tengchong County, Southwest China. Parasitol. Res. 2020, 119, 1259–1269. [Google Scholar] [CrossRef]
- Hao, L.; Yuan, D.; Li, S.; Jia, T.; Guo, L.; Hou, W.; Lu, Z.; Mo, X.; Yin, J.; Yang, A.; et al. Detection of Theileria spp. in ticks, sheep keds (Melophagus ovinus), and livestock in the eastern Tibetan Plateau, China. Parasitol. Res. 2020, 119, 2641–2648. [Google Scholar] [CrossRef]
- Patial, V.; Gupta, T.; Angaria, S.; Bali, D.; Katoch, A.; Gautam, M.; Singh, N.K.; Sharma, M.; Chahota, R. Theileria orientalis outbreak in an organized cattle breeding farm. Vet. Parasitol. Reg. Stud. Rep. 2021, 24, 100572. [Google Scholar] [CrossRef]
- Rehman, A.; Conraths, F.J.; Sauter-Louis, C.; Krücken, J.; Nijhof, A.M. Epidemiology of tick-borne pathogens in the semi-arid and the arid agroecological zones of Punjab province, Pakistan. Transbound. Emerg. Dis. 2019, 66, 526–536. [Google Scholar] [CrossRef]
- Khukhuu, A.; Lan, D.T.B.; Long, P.T.; Ueno, A.; Li, Y.; Luo, Y.; de Macedo, A.C.C.; Matsumoto, K.; Inokuma, H.; Kawazu, S.-I.; et al. Molecular Epidemiological Survey of Theileria orientalis in Thua Thien Hue Province, Vietnam. J. Vet. Med. Sci. 2011, 73, 701–705. [Google Scholar] [CrossRef]
- Ota, N.; Mizuno, D.; Kuboki, N.; Igarashi, I.; Nakamura, Y.; Yamashina, H.; Hanzaike, T.; Fujii, K.; Onoe, S.; Hata, H.; et al. Epidemiological Survey of Theileria orientalis Infection in Grazing Cattle in the Eastern Part of Hokkaido, Japan. J. Vet. Med. Sci. 2009, 71, 937–944. [Google Scholar] [CrossRef]
- Scoles, G.A.; Ueti, M.W.; Noh, S.M.; Knowles, D.P.; Palmer, G.H. Conservation of Transmission Phenotype of Anaplasma marginale (Rickettsiales: Anaplasmataceae) Strains Among Dermacentor and Rhipicephalus Ticks (Acari: Ixodidae). J. Med. Èntomol. 2007, 44, 484–491. [Google Scholar] [CrossRef]
- Howell, J.M.; Ueti, M.W.; Palmer, G.H.; Scoles, G.A.; Knowles, D.P. Transovarial Transmission Efficiency of Babesia bovis Tick Stages Acquired by Rhipicephalus (Boophilus) microplus during Acute Infection. J. Clin. Microbiol. 2007, 45, 426–431. [Google Scholar] [CrossRef]
- Almazán, C.; Scimeca, R.C.; Reichard, M.V.; Mosqueda, J. Babesiosis and Theileriosis in North America. Pathogens 2022, 11, 168. [Google Scholar] [CrossRef]
- Ueti, M.W.; Palmer, G.H.; Kappmeyer, L.S.; Statdfield, M.; Scoles, G.A.; Knowles, D.P. Ability of the Vector Tick Boophilus microplus to Acquire and Transmit Babesia equi following Feeding on Chronically Infected Horses with Low-Level Parasitemia. J. Clin. Microbiol. 2005, 43, 3755–3759. [Google Scholar] [CrossRef]
- Ueti, M.W.; Palmer, G.H.; Scoles, G.A.; Kappmeyer, L.S.; Knowles, D.P. Persistently Infected Horses Are Reservoirs for Intrastadial Tick-Borne Transmission of the Apicomplexan Parasite Babesia equi. Infect. Immun. 2008, 76, 3525–3529. [Google Scholar] [CrossRef] [PubMed]
- Schnittger, L.; Ganzinelli, S.; Bhoora, R.; Omondi, D.; Nijhof, A.M.; Florin-Christensen, M. The Piroplasmida Babesia, Cytauxzoon, and Theileria in farm and companion animals: Species compilation, molecular phylogeny, and evolutionary insights. Parasitol. Res. 2022, 121, 1207–1245. [Google Scholar] [CrossRef] [PubMed]
- Bergren, N.A.; Kading, R.C. The Ecological Significance and Implications of Transovarial Transmission among the Vector-Borne Bunyaviruses: A Review. Insects 2018, 9, 173. [Google Scholar] [CrossRef] [PubMed]
- Schnittger, L.; Rodriguez, A.E.; Florin-Christensen, M.; Morrison, D.A. Babesia: A world emerging. Infect. Genet. Evol. 2012, 12, 1788–1809. [Google Scholar] [CrossRef] [PubMed]
- Jalovecka, M.; Hajdusek, O.; Sojka, D.; Kopacek, P.; Malandrin, L. The Complexity of Piroplasms Life Cycles. Front. Cell. Infect. Microbiol. 2018, 8, 248. [Google Scholar] [CrossRef]
- Ravindran, R.; Hembram, P.K.; Kumar, G.S.; Kumar, K.G.A.; Deepa, C.K.; Varghese, A. Transovarial transmission of pathogenic protozoa and rickettsial organisms in ticks. Parasitol. Res. 2023, 122, 691–704. [Google Scholar] [CrossRef]
- Peckle, M.; Santos, H.; Pires, M.; Silva, C.; Costa, R.; Vitari, G.; Camilo, T.; Meireles, N.; Paulino, P.; Massard, C. Dynamics of Theileria equi Infection in Rhipicephalus (Boophilus) microplus during the Parasitic Phase in a Chronically Infected Horse. Pathogens 2022, 11, 525. [Google Scholar] [CrossRef]
- Olds, C.L.; Mason, K.L.; Scoles, G.A. Rhipicephalus appendiculatus ticks transmit Theileria parva from persistently infected cattle in the absence of detectable parasitemia: Implications for East Coast fever epidemiology. Parasites Vectors 2018, 11, 126. [Google Scholar] [CrossRef]
- Low, V.L.; Tay, S.T.; Kho, K.L.; Koh, F.X.; Tan, T.K.; Lim, Y.A.L.; Ong, B.L.; Panchadcharam, C.; Norma-Rashid, Y.; Sofian-Azirun, M. Molecular characterisation of the tick Rhipicephalus microplus in Malaysia: New insights into the cryptic diversity and distinct genetic assemblages throughout the world. Parasites Vectors 2015, 8, 341. [Google Scholar] [CrossRef]
- Estrada-Peña, A.; Venzal, J.M.; Nava, S.; Mangold, A.; Guglielmone, A.A.; Labruna, M.B.; de la Fuente, J. Reinstatement of Rhipicephalus (Boophilus) australis(Acari: Ixodidae) with Redescription of the Adult and Larval Stages. J. Med. Èntomol. 2012, 49, 794–802. [Google Scholar] [CrossRef]
- Pereira, D.F.S.; Ribeiro, H.S.; Gonçalves, A.A.M.; da Silva, A.V.; Lair, D.F.; de Oliveira, D.S.; Boas, D.F.V.; Conrado, I.d.S.S.; Leite, J.C.; Barata, L.M.; et al. Rhipicephalus microplus: An overview of vaccine antigens against the cattle tick. Ticks Tick-Borne Dis. 2022, 13, 101828. [Google Scholar] [CrossRef]
- Cumbie, A.N.; Trimble, R.N.; Eastwood, G. Pathogen Spillover to an Invasive Tick Species: First Detection of Bourbon Virus in Haemaphysalis longicornis in the United States. Pathogens 2022, 11, 454. [Google Scholar] [CrossRef]
- Wright, C.L.; Sonenshine, D.E.; Gaff, H.D.; Hynes, W.L. Rickettsia parkeri Transmission to Amblyomma americanum by Cofeeding with Amblyomma maculatum (Acari: Ixodidae) and Potential for Spillover. J. Med. Entomol. 2015, 52, 1090–1095. [Google Scholar] [CrossRef]
- Patrican, L.A. Acquisition of Lyme disease spirochetes by cofeeding Ixodes scapularis ticks. Am. J. Trop. Med. Hyg. 1997, 57, 589–593. [Google Scholar] [CrossRef]
- Belli, A.; Sarr, A.; Rais, O.; Rego, R.O.M.; Voordouw, M.J. Ticks infected via co-feeding transmission can transmit Lyme borreliosis to vertebrate hosts. Sci. Rep. 2017, 7, 5006. [Google Scholar] [CrossRef]

| Calf | 1 0–7 DPI | 2 8–14 DPI | 3 15–21 DPI | 4 22–28 DPI | 5 29–35 DPI | 6 36–42 DPI | 7 43–49 DPI | 8 50–56 DPI | 9 57–63 DPI | 10 64–70 DPI | 11 71–77 DPI | 12 78–84 DPI | 13 85–91 DPI | 14 92–98 DPI | 15 99–105 DPI | 16 106–112 DPI | 17 113–119 DPI |
|---|---|---|---|---|---|---|---|---|---|---|---|---|---|---|---|---|---|
| 1 | − | − | +/− | + | +/− | + | + | + | + | + | +/− | + | + | + | + | + | + |
| 2 | − | − | − | − | − | − | − | − | − | − | − | − | − | − | − | − | − |
| 3 | − | − | − | − | − | − | − | − | − | − | − | − | − | − | − | − | − |
| Tick Batch | Females Tested | Males Tested | Number Positive |
|---|---|---|---|
| Group 1 Adults | 6 | 9 | 0 |
| Group 2 Adults | 7 | 8 | 0 |
| Group 1 Larvae | ~20,000 larval ticks | Batch negative | |
| Group 2 Larvae | ~20,000 larval ticks | Batch negative | |
Disclaimer/Publisher’s Note: The statements, opinions and data contained in all publications are solely those of the individual author(s) and contributor(s) and not of MDPI and/or the editor(s). MDPI and/or the editor(s) disclaim responsibility for any injury to people or property resulting from any ideas, methods, instructions or products referred to in the content. |
© 2023 by the authors. Licensee MDPI, Basel, Switzerland. This article is an open access article distributed under the terms and conditions of the Creative Commons Attribution (CC BY) license (https://creativecommons.org/licenses/by/4.0/).
Share and Cite
Onzere, C.K.; Herndon, D.R.; Hassan, A.; Oyen, K.; Poh, K.C.; Scoles, G.A.; Fry, L.M. A U.S. Isolate of Theileria orientalis Ikeda Is Not Transstadially Transmitted to Cattle by Rhipicephalus microplus. Pathogens 2023, 12, 559. https://doi.org/10.3390/pathogens12040559
Onzere CK, Herndon DR, Hassan A, Oyen K, Poh KC, Scoles GA, Fry LM. A U.S. Isolate of Theileria orientalis Ikeda Is Not Transstadially Transmitted to Cattle by Rhipicephalus microplus. Pathogens. 2023; 12(4):559. https://doi.org/10.3390/pathogens12040559
Chicago/Turabian StyleOnzere, Cynthia K., David R. Herndon, Amany Hassan, Kennan Oyen, Karen C. Poh, Glen A. Scoles, and Lindsay M. Fry. 2023. "A U.S. Isolate of Theileria orientalis Ikeda Is Not Transstadially Transmitted to Cattle by Rhipicephalus microplus" Pathogens 12, no. 4: 559. https://doi.org/10.3390/pathogens12040559
APA StyleOnzere, C. K., Herndon, D. R., Hassan, A., Oyen, K., Poh, K. C., Scoles, G. A., & Fry, L. M. (2023). A U.S. Isolate of Theileria orientalis Ikeda Is Not Transstadially Transmitted to Cattle by Rhipicephalus microplus. Pathogens, 12(4), 559. https://doi.org/10.3390/pathogens12040559

